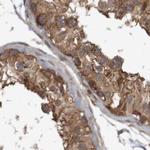
ARHGEF11 Antibody in Immunohistochemistry (IHC)

Search
Invitrogen
ARHGEF11 Polyclonal Antibody
{{$productOrderCtrl.translations['antibody.pdp.commerceCard.promotion.promotions']}}
{{$productOrderCtrl.translations['antibody.pdp.commerceCard.promotion.viewpromo']}}
{{$productOrderCtrl.translations['antibody.pdp.commerceCard.promotion.promocode']}}: {{promo.promoCode}} {{promo.promoTitle}} {{promo.promoDescription}}. {{$productOrderCtrl.translations['antibody.pdp.commerceCard.promotion.learnmore']}}
图: 1 / 6
ARHGEF11 Antibody (PA5-52776) in IHC

Please note: We are reviewing Western blot images included in the antibody testing data in our catalog, including those provided by third parties. Unless expressly labeled or annotated as “raw-unedited”, Western blot images included in the antibody testing data in our catalog may have been edited, optimized or otherwise adjusted for presentation.
产品信息
PA5-52776
种属反应
宿主/亚型
分类
类型
抗原
偶联物
形式
浓度
规格
纯化类型
保存液
内含物
保存条件
运输条件
RRID
产品详细信息
Immunogen sequence: LQAEIDSRLR NSEDARGVLC EAQEAAMPEI QEQIHDYRTK RTLGLGSLYG ENDLLDLDGD PLRERQVAEK QLAALGDILS KYEEDRSAPM DFALNTYMSH AGIRLREARP SNTAEKAQSA PDKDKWLPFF PKTKKSSNSK KEQDA
Highest antigen sequence identity to the following orthologs: Mouse - 90%, Rat - 88%.
靶标信息
ARHGEF11 is a 1527 amino acid protein with tandem dbl homology and pleckstrin homology domains, PDZ domain, two proline rich sequences and a regulatory G protein-signaling (RGS) sequence. It acts as guanine nucleotide exchange factor (GEF) for RhoA GTPase, but not for RAC1 or CDC42 and acts as GTPase-activating protein (GAP) for GNA12 and GNA13. It forms a complex with G proteins and stimulates neurite through retraction Rho-dependent signals. ARHGEF11 increases glutamate transport 4-fold. It interacts with EAAT4 and modulates its uptake activity and perisynaptic distribution at glutamatergic synapses. It is known to induce the reorganization of the actin cytoskeleton and its overexpression induces the formation of membrane ruffling and filopodia. It is ubiquitously expressed, in brain, lung, liver, kidney and skeletal muscle.
仅用于科研。不用于诊断过程。未经明确授权不得转售。
篇参考文献 (0)
生物信息学
蛋白别名: PDZ-RhoGEF; Rho guanine nucleotide exchange factor 11; RP11-356J7.2
基因别名: ARHGEF11; KIAA0380
Entrez Gene ID: (Human) 9826




